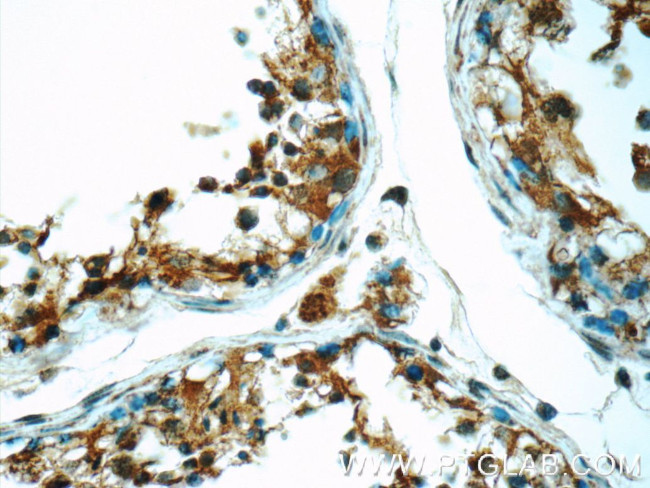
ODF1 Antibody in Immunohistochemistry (Paraffin) (IHC (P))
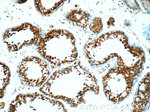
ODF1 Antibody in Immunohistochemistry (Paraffin) (IHC (P))

Search
Proteintech
ODF1 Polyclonal Antibody
{{$productOrderCtrl.translations['antibody.pdp.commerceCard.promotion.promotions']}}
{{$productOrderCtrl.translations['antibody.pdp.commerceCard.promotion.viewpromo']}}
{{$productOrderCtrl.translations['antibody.pdp.commerceCard.promotion.promocode']}}: {{promo.promoCode}} {{promo.promoTitle}} {{promo.promoDescription}}. {{$productOrderCtrl.translations['antibody.pdp.commerceCard.promotion.learnmore']}}
产品信息
24736-1-AP
种属反应
宿主/亚型
分类
类型
抗原
偶联物
形式
浓度
规格
纯化类型
保存液
内含物
保存条件
运输条件
产品详细信息
Immunogen sequence: MAALSCLLD SVRRDIKKVD RELRQLRCID EFSTRCLCDL YMHPYCCCDL HPYPYCLCYS KRSRSCGLCD LYPCCLCDYK LYCLRPSLRS LERKAIRAIE DEKRELAKLR RTTNRILASS CCSSNILGSV NVCGFEPDQV KVRVKDGKVC VSAERENRYD CLGSKKYSYM NICKEFSLPP CVDEKDVTYS YGLGSCVKIE SPCYPCTSPC SPCSPCNPCN PCSPCNPCSP YDPCNPCYPC GSRFSCRKMI L (1-250 aa encoded by BC104457)
靶标信息
The outer dense fibers are cytoskeletal structures that surround the axoneme in the middle piece and principal piece of the sperm tail. The fibers function in maintaining the elastic structure and recoil of the sperm tail as well as in protecting the tail from shear forces during epididymal transport and ejaculation. Defects in the outer dense fibers lead to abnormal sperm morphology and infertility. The human outer dense fibers contains at least 10 major proteins and this gene encodes the main protein.
仅用于科研。不用于诊断过程。未经明确授权不得转售。
生物信息学
蛋白别名: cancer/testis antigen 133; Heat shock protein beta-10; Heat shock protein family B member 10; HspB10; outer dense fiber of sperm tails, 27-kD; Outer dense fiber protein 1; outer dense fiber protein-1; Protein RT7; RTS 5/1; Sperm outer dense fiber major protein 1
基因别名: CT133; HSPB10; ODF; ODF1; ODF2; ODF27; ODFP; ODFPG; ODFPGA; ODFPGB; RT7; SODF
UniProt ID: (Human) Q14990, (Rat) P21769
Entrez Gene ID: (Human) 4956, (Mouse) 18285, (Rat) 24610